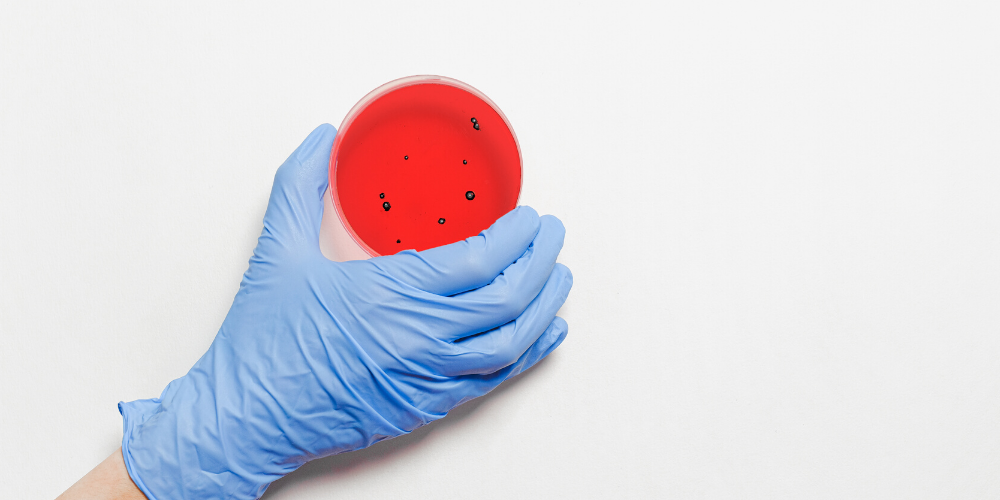

«Die Covid-19 Pandemie hat schweizweit zu einer Krise geführt. Nach zwei Monaten Ausnahmezustand bleibt bereits die Erkenntnis, dass Gesellschaft, Wirtschaft und die staatlichen Ebenen überrascht und in ihren Grundfesten erschüttert worden sind. Die Pandemie hat aber auch mit aller Deutlichkeit aufgezeigt, dass selbst unser hochstehendes Gesundheitssystem an seine Grenzen stösst», sagt die CVP-GLP Fraktion des Kanton St.Gallen.
Weiter heisst es: Die in Pandemiesituationen erforderliche koordinierte medizinische Versorgung wies grosse Mängel auf. Zudem hat sich die seit Jahren gehäuft auftretende Verknappung von Medikamenten und Gerätschaften für die Grundversorgung in den vergangenen Monaten weiter verschärft. Das medizinische Angebot in Spitälern und Kliniken musste teilweise heruntergefahren werden, weil Geräte und Medikamente fehlten.
Zivilschutz und Betten
Ein wichtiger Teil des Pandemieplanes, welcher 2004 durch den Bund vorgelegt wurde, war die medizinische Versorgung. Demnach war es Aufgabe der kantonalen Behörden, für genügend Kapazitäten in den Spitälern zu sorgen und einen allfälligen Mehrbedarf an Medikamenten sowie medizinischen Geräten und Instrumenten bereitzustellen. Die Koordination der Gesundheitsdienste mit den Aufgaben aller zivilen und militärischen Stellen in Krisensituation war mit ein Thema, wurde jedoch nicht konsequent weiterverfolgt. Im Gegenteil - der Sanitätsdienst des Zivilschutzes wurde beispielsweise im Jahre 2004 sogar ersatzlos abgeschafft. Ebenso unklar definiert war die Aufgabe der Spitäler in Bezug auf die Bereitstellung von Infrastrukturen und Betten für Notlagen und Katastrophenfälle
Medikamenten-Versorgung gefährdet
Die Verknappung der Medikamente ist die Folge der globalen Logistikketten, welche die Versorgungssicherheit im Gesundheitswesen ernsthaft gefährden. Obwohl die Ressourcen für die Medikamentenherstellung im Inland vorhanden sein sollten, ist die Abhängigkeit vom Ausland zu hoch. Weitere wichtige Erkenntnisse konnten zur notwendigen Infrastruktur sowie über die Notwendigkeit der systemrelevanten Berufe im Gesundheitswesen wie auch in anderen Branchen gemacht werden.
St.Gallen müsse besser gerüstet sein
Auf diesen Erkenntnissen aufbauend müsse eine detaillierte Analyse erfolgen, der Handlungsbedarf erkannt und die notwendigen Massnahmen in die Wege geleitet werden. St.Gallen muss für künftige Pandemiesituationen besser gerüstet sein. Die CVP-GLP Fraktion bittet die Regierung dies in einem Bericht umfassend aufzuarbeiten.
Insbesondere soll aufgezeigt werden,
- wie die kantonalen und regionalen Führungsstäbe ihre Aufgaben bei der Bewältigung der Krise wahrgenommen haben, wie die Abläufe und die Struktur verbessert werden können und wie eine weitere Krise besser zu meistern ist
- wie künftig eine ausreichende Versorgung mit Medikamenten und Geräten allgemein und ganz besonders für Krisensituationen sichergestellt wird
- wie das Fachpersonal im Gesundheitswesen für Pandemiesituationen gezielt ausgebildet werden und in genügender Anzahl zur Verfügung stehen soll
- wie die verschiedenen Schutzorganisationen auf Pandemiesituationen vorbereitet werden und welche Aufgaben sie in Koordination mit den Akteuren im Gesundheitswesen zu erbringen haben
- wie die in einer Pandemiesituation zu treffenden behördlichen Massnahmen wirtschafts- und sozialverträglicher gestaltet werden können
- wie der Kanton seine Kommunikation in einer Pandemiesituation gegenüber den Akteuren und der Bevölkerung optimieren kann
- welche zusätzlichen Infrastrukturen nebst den bestehenden Infrastrukturen des Gesundheitswesen für künftige Pandemiesituationen notwendig sind